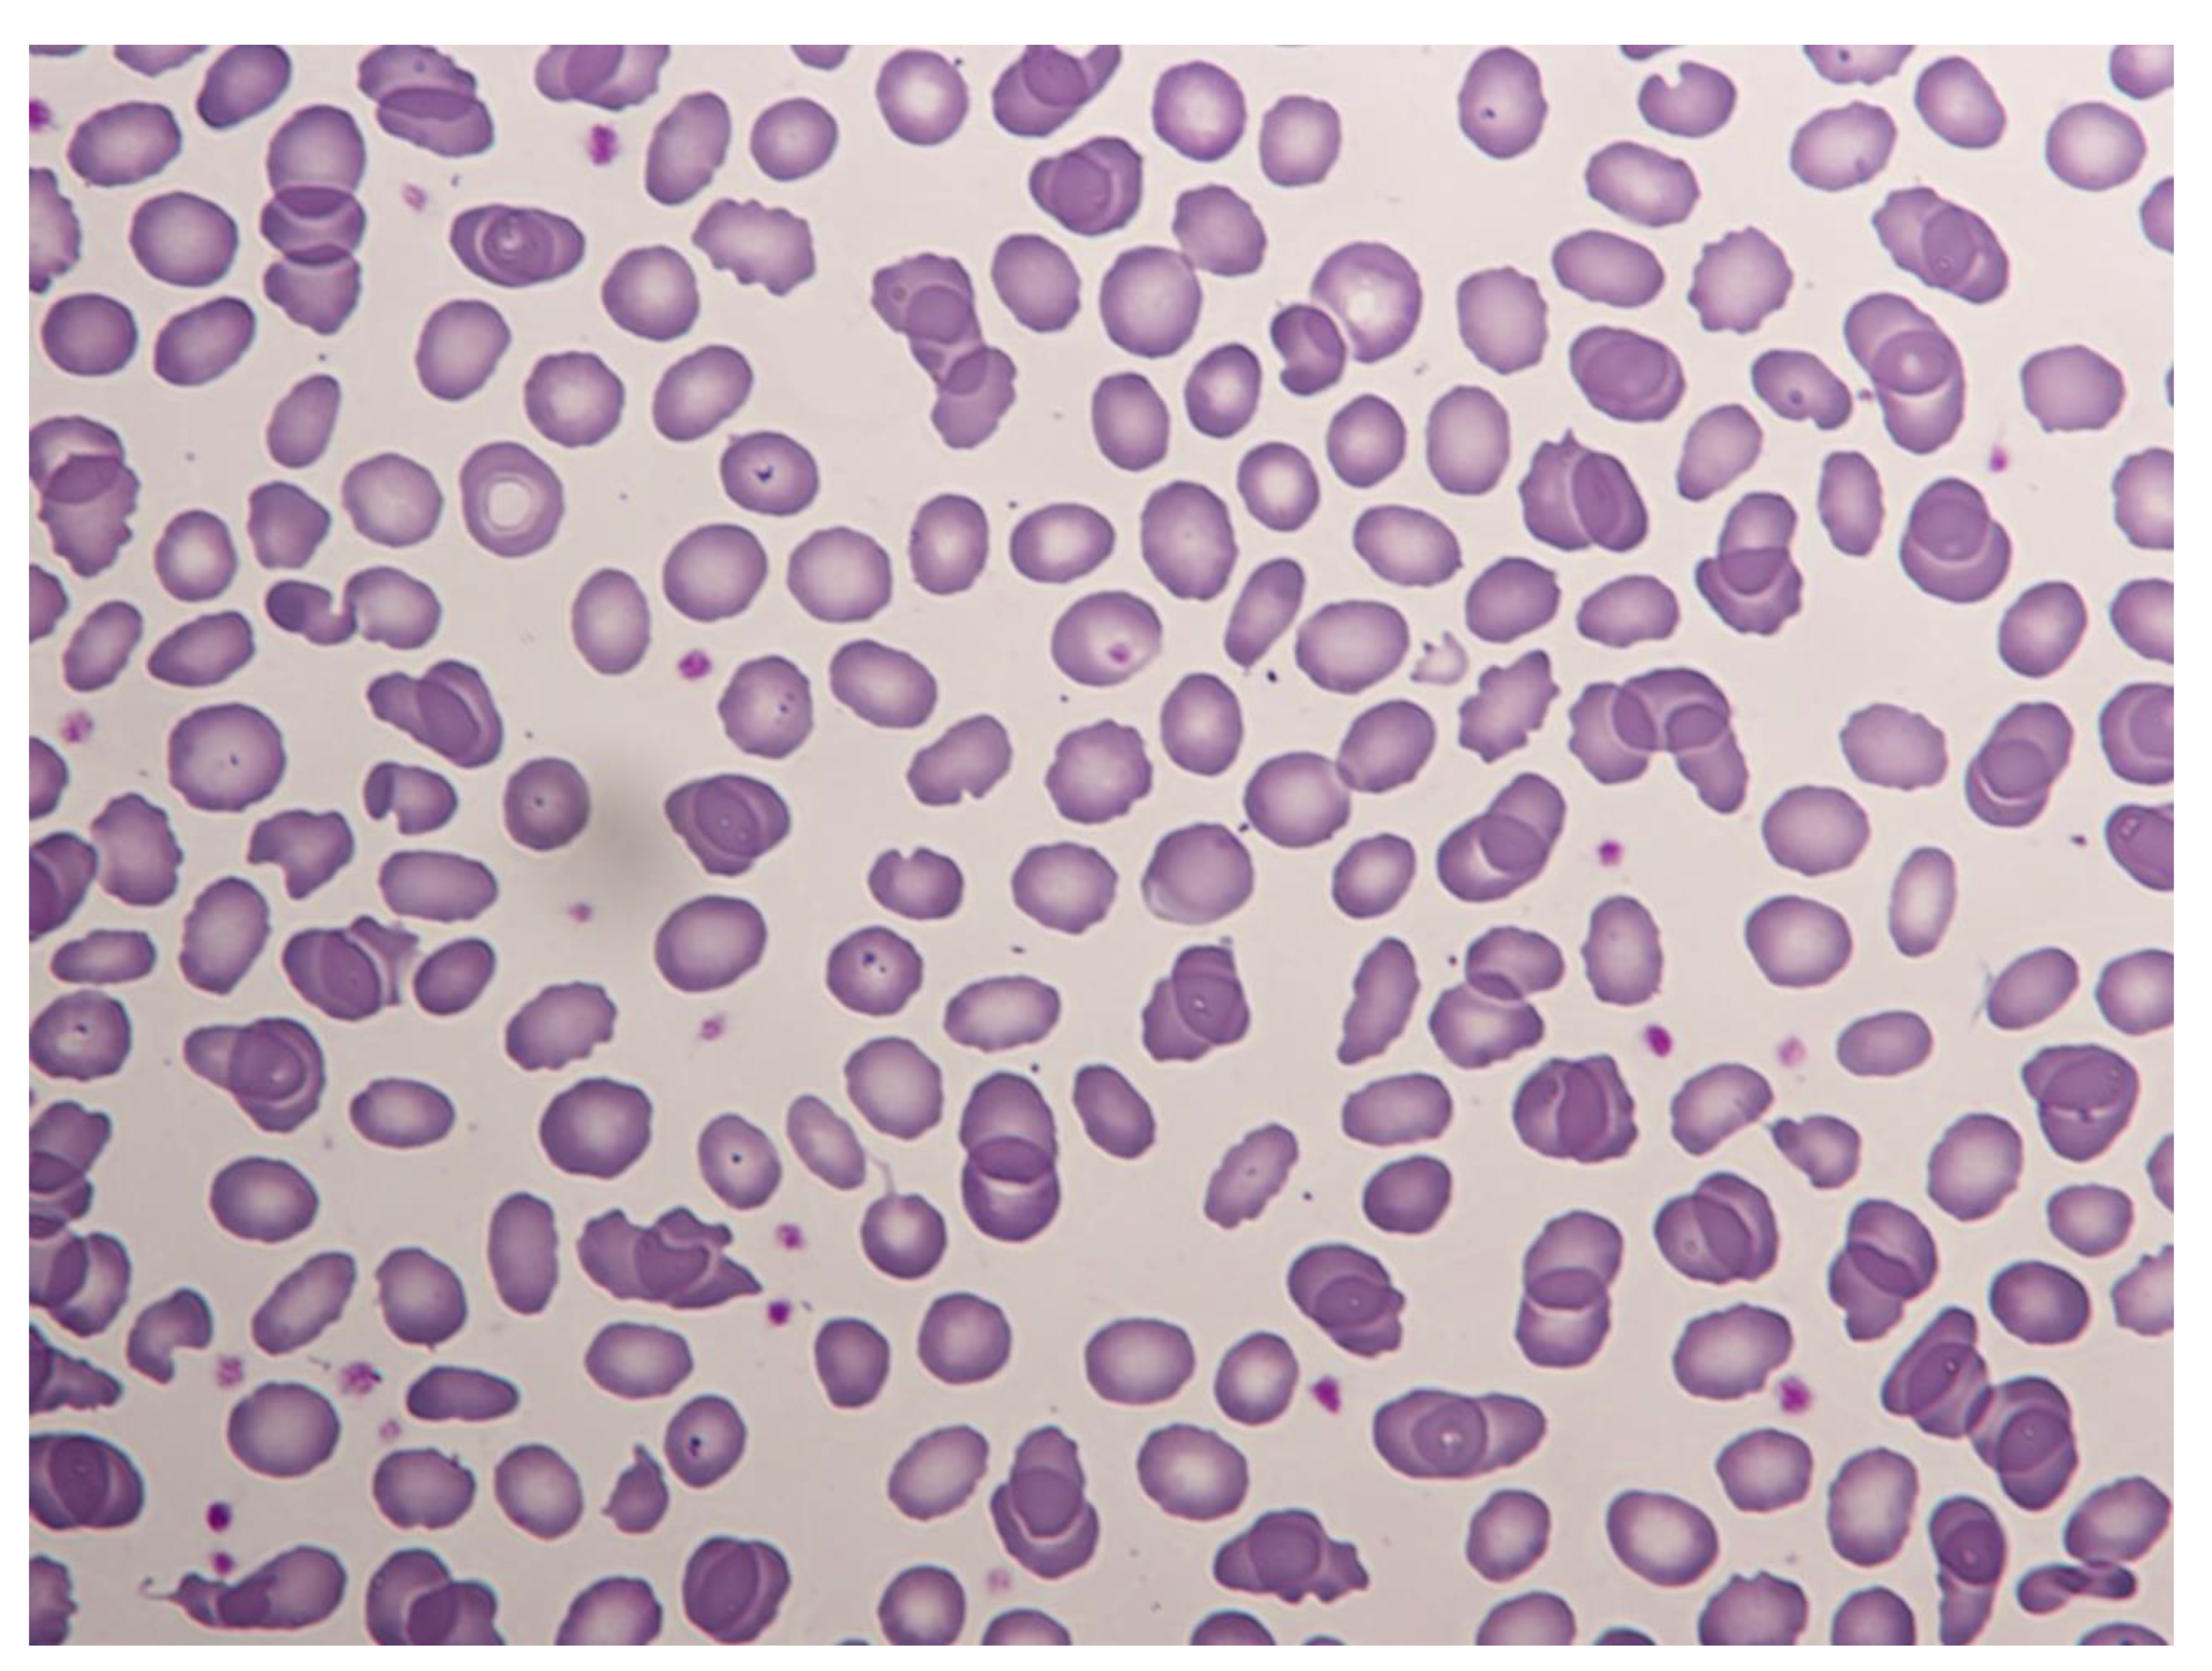
Hematolrep 14 00043 g001

Case Report: α-Spectrin Mutation Associated with αLELY Polymorphism Responsible for Hereditary Pyropoikilocytosis
Abstract
1. Introduction
2. Case Report
3. Discussion
Author Contributions
Funding
Informed Consent Statement
Conflicts of Interest
References
- Gaetani, M.; Mootien, S.; Harper, S. Structural and functional effects of hereditary hemolytic anemia-associated point mutations in the alpha spectrin tetramer site. Blood 2008, 111, 5712–5720. [Google Scholar] [CrossRef] [PubMed]
- Ramos, M.C.; Schafernak, K.T.; Peterson, L.C. Hereditary pyropoikilocytosis: A rare but potentially severe form of congenital hemolytic anemia. J. Pediatr. Hematol. Oncol. 2007, 29, 128–129. [Google Scholar] [CrossRef] [PubMed]
- Online Mendelian Inheritance in Man. OMIM. Johns Hopkins University. Available online: https://www.omim.org/entry/182860 (accessed on 17 July 2021).
- Zarkowsky, H.S.; Mohandas, N.; Speaker, C.B.; Shohet, S.B. A congenital haemolytic anaemia with thermal sensitivity of the erythrocyte membrane. Br. J. Haemat. 1975, 29, 537–543. [Google Scholar] [CrossRef] [PubMed]
- King, M.J.; Zanella, A. Hereditary red cell membrane disorders and laboratory diagnostic testing. Int. J. Lab. Hematol. 2013, 35, 237–243. [Google Scholar] [CrossRef] [PubMed]
- Da Costa, L.; Galimand, J.; Fenneteau, O. Hereditary spherocytosis, elliptocytosis, and other red cell membrane disorders. Blood Rev. 2013, 27, 167–178. [Google Scholar] [CrossRef]
- Narla, J.; Mohandas, N. Red cell membrane disorders. Int. J. Lab. Hematol. 2017, 39 (Suppl. 1), 47–52. [Google Scholar] [CrossRef] [PubMed]
- Garbarz, M.; Lecomte, M.C.; Féo, C. Hereditary pyropoikilocytosis and elliptocytosis in a white French family with the spectrin alpha I/74 variant related to a CGT to CAT codon change (Arg to His) at position 22 of the spectrin alpha I domain. Blood 1990, 75, 1691–1698. [Google Scholar] [CrossRef]
- Baklouti, F.; Marechal, J.; Morle, L. Occurrence of the alpha-I 22 arg-to-his (CGT-to-CAT) spectrin mutation in Tunisia: Potential association with severe elliptopoikilocytosis. Br. J. Haemat. 1991, 78, 108–113. [Google Scholar] [CrossRef] [PubMed]
- Niss, O.; Chonat, S.; Dagaonkar, N. Genotype-phenotype correlations in hereditary elliptocytosis and hereditary pyropoikilocytosis. Blood Cells Mol. Dis. 2016, 61, 4–9. [Google Scholar] [CrossRef]

| Parameter | Patient (13-Day-Old) | Patient (2-Year-Old) | Mother | Father |
|---|---|---|---|---|
| RBC (×109/L) | 2.6 | 4.4 | 4.7 | 5.0 |
| Hb (g/L) | 60 | 110 | 125 | 147 |
| MCV (fL) | 70 | 74 | 79.7 | 83.8 |
| MCH (pg) | 24 | 25.1 | 26.5 | 29.7 |
| RDW(%) | 16 | 15 | 13.5 | 12.1 |
| Reticulocytes (%) | 5.9 | 6.23 | 1.91 | 1.88 |
| Leucocytes (×109/L) | 6000 | 4830 | 8170 | 5800 |
| Platelets (×109/L) | 302 | 278 | 242 | 222 |
| RBC osmotic fragility | Tendency to hyporesistance/Inconclusive | --- | ---- | --- |
| EMA | Decrease of 11.5% | --- | --- | --- |
Publisher’s Note: MDPI stays neutral with regard to jurisdictional claims in published maps and institutional affiliations. |
© 2022 by the authors. Licensee MDPI, Basel, Switzerland. This article is an open access article distributed under the terms and conditions of the Creative Commons Attribution (CC BY) license (https://creativecommons.org/licenses/by/4.0/).
Share and Cite
Sánchez Villalobos, M.; Salido Fiérrez, E.; Martínez Nieto, J.; García Garay, M.C.; Beltrán Videla, A.; Pérez Oliva, A.B.; Blanquer Blanquer, M.; Moraleda Jiménez, J.M. Case Report: α-Spectrin Mutation Associated with αLELY Polymorphism Responsible for Hereditary Pyropoikilocytosis. Hematol. Rep. 2022, 14, 300-304. https://doi.org/10.3390/hematolrep14040043
Sánchez Villalobos M, Salido Fiérrez E, Martínez Nieto J, García Garay MC, Beltrán Videla A, Pérez Oliva AB, Blanquer Blanquer M, Moraleda Jiménez JM. Case Report: α-Spectrin Mutation Associated with αLELY Polymorphism Responsible for Hereditary Pyropoikilocytosis. Hematology Reports. 2022; 14(4):300-304. https://doi.org/10.3390/hematolrep14040043
Chicago/Turabian StyleSánchez Villalobos, María, Eduardo Salido Fiérrez, Jorge Martínez Nieto, Mª Carmen García Garay, Asunción Beltrán Videla, Ana Belen Pérez Oliva, Miguel Blanquer Blanquer, and José María Moraleda Jiménez. 2022. "Case Report: α-Spectrin Mutation Associated with αLELY Polymorphism Responsible for Hereditary Pyropoikilocytosis" Hematology Reports 14, no. 4: 300-304. https://doi.org/10.3390/hematolrep14040043
APA StyleSánchez Villalobos, M., Salido Fiérrez, E., Martínez Nieto, J., García Garay, M. C., Beltrán Videla, A., Pérez Oliva, A. B., Blanquer Blanquer, M., & Moraleda Jiménez, J. M. (2022). Case Report: α-Spectrin Mutation Associated with αLELY Polymorphism Responsible for Hereditary Pyropoikilocytosis. Hematology Reports, 14(4), 300-304. https://doi.org/10.3390/hematolrep14040043

